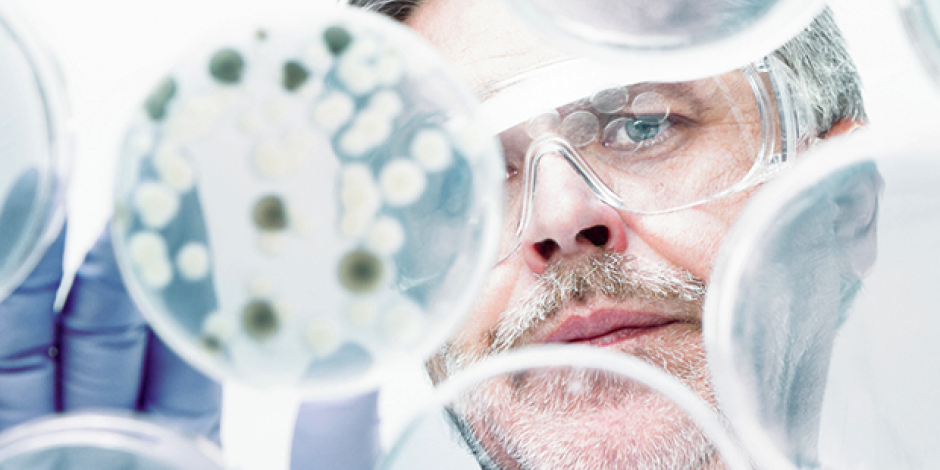

Acum câteva zile am început să pregătim articolul de mai jos, dar nu am avut timpul să-l terminăm și să-l publicăm. Motivul? Am fost ocupați cu organizarea unei întâlniri cu delegația venită de la Universitatea din Vlore, Albania, cu care ne-am întâlnit pentru a încheia un parteneriat pe termen lung și pentru a pregăti câteva acțiuni comune – un pachet de cursuri ”altfel” pentru studenți din mai multe țări europene și cea de a doua ediție aConferinței Internaționale ”Cercetare și inovare” (prima conferință a avut loc în Vlore, în Decembrie 2021). Timp de trei zile ne-am întâlnit nu numai cu membrii delegației albaneze, dar și cu mulți cercetători români, cu instituții și organizații din București și din Brașov. În timpul discuțiilor noastre au apărut și teme legate de ideea articolului de mai jos – la ce nivel a ajuns acum tehnologia și cum va evolua în viitor. Unul dintre primii care ne-au aruncat provocarea a fost Domnul Prof. Alexandru Mironov, președinte al Clubului Știință și Tehnică –https://stiintasitehnica.com/cluburi/ și al Institutului European pentru Cercetări Multidisciplinare.
Domnia sa ne-a vorbit, ca de obicei, despre cucerirea spațiului cosmic, despre posibilitatea întâlnirilor cu civilizații din afara Sistemului Solar și despre Caravana Știință și Imaginație care se va desfășura în perioada Martie-Decembrie 2022, fiind organizată de Cluburile Știință și Tehnică din mai multe orașe. Cel de al doilea a fost reprezentantul Academiei Europene a Regiunilor, care ne-a vorbit ieri, la Brașov despre evoluțiile inteligenței artificiale, despre cele din domeniul roboților cu aspect uman, dar și despre cea de a doua ediție a Concursului și Conferințelor Digital Nerds (http://digitalnerdscontest.ro/), care va avea loc peste câteva săptămâni, fiind organizate de EAR, în parteneriat cu multe alte organizații din România și alte țări europene.
Gata, v-am povestit pe scurt ce am făcut în aceste zile – acum revenim la articolul nostru. Sperăm să vă provoace și pe voi la dezbateri la fel de animate ca cele pe care le-am avut noi în aceste câteva zile când am vorbit despre formare, știință și cercetare.
În aceste zile, când războiul face ravagii în țara vecină, peste tot vezi sau întâlnești adulți care încearcă să-și imagineze ce se va întâmpla în viitor – pe termen scurt sau lung. Puteți să fiți siguri că și majoritatea copiilor se gândesc la viitor – și nu doar pentru că acum e o situație cu totul specială și, pentru mulți înfricoșătoare. Ci pentru că este normal să te gândești la viitor și să încerci să-ți imaginezi cum va arăta acest viitor, pentru tine personal și pentru întreaga societate în care trăiești. Și noi credem că aceste preocupări pot fi aduse în clase într-un mod în care poate contribui atât la învățare cât și la bunăstarea emoțională a elevilor. Creați-le elevilor voștri posibilitatea de a vorbi în mod organizat despre viitor, în cadrul unor lecții legate de istoria omenirii, adăugând idei cum sunt cele de mai jos, propuse de Jason Tomaszewski, editor asociat la revista Education World:
Să prezicem viitorul
Timp de sute de ani oamenii au încercat să prezică viitorul. Cu toate acestea, chiar și maeștri ai previziunilor – ca de exemplu Nostradamus – au făcut în cel mai bun caz previziuni vagi și, în cazurile cele mai rele, unele cu totul greșite.
Când determinăm acuratețea unor predicții făcute cu mult timp în urmă, acest lucru ne spune multe nu numai despre contextul istoric în care au trăit oamenii acum zeci sau sute de ani în urmă, dar ne și oferă indicii despre ce se va întâmpla în viitor. Ajutați-i pe elevi să-și utilizeze gândirea critică pentru a-și imagina ce a fost în mintea oamenilor care au trăit în secolul 20 și să prezică ce le va aduce viitorul.
Nivelul de clasă: gimnaziu și liceu (5-12)
Obiectivele de învățare pentru elevi
Elevii citesc diferitele preziceri (făcute de oamenii care au trăit în primii ani ai Secolului 20) despre cum au crezut ei că va arăta viața în anul 2.000. Copiii vor compara acele predicții cu ce s-a întâmplat de fapt și apoi vor face propriile speculații despre ce se va întâmpla în viitor.
Pregătirea
În primul rând te invităm să te familiarizezi cu câteva predicții despre cum va arăta viața oamenilor în jurul anului 2.000 – făcute de oameni care au trăit în primii ani ai secolului 20. Următoarele predicții au fost publicate prima dată de către Jurnalul Casa Doamnelor* (Ladies’ Home Journal), ediția din Decembrie 1900 și au fost extrase dintr-o colecție de publicații franceze, citate și de publicații de la noi**:
* http://yorktownhistory.org/wp-content/archives/homepages/1900_predictions.htm
* https://www.omofon.com/10-predictii-ale-lui-nikola-tesla-care-s-au-dovedit-a-fi-adevarate
** https://ziare.com/magazin/inedit/predictii-mai-vechi-de-100-de-ani-care-s-au-adeverit-1144491
** https://dominiccristian.blogspot.com/2015/12/anii-1900.html
În anul 2000:
Toți vor dori să devină americani
“Probabil că în anul 2000 vor fi între 350,000,000 și 500,000,000 de oameni în America. Nicaragua va cere să fie primită în Statele Unite Americane, după completarea marelui canal (Panama, n.n.). Mexic va fi următoarea țară care se va alătura SUA. Europa, care va căuta mai multe teritorii la sud de noi [după ce se vor alătura Uniunii,] îi va provoca pe oamenii din republicile din America de Sud să voteze ca și țările lor să se alăture SUA.”
Vom fi o societate cu specimene bine dezvoltate fizic.
“Gimnastica va începe încă de la creșă, unde jucăriile și jocurile vor fi concepute pentru întărirea mușchilor. În școli, exercițiile fizice vor fi obligatorii. Fiecare școală, colegiu și comunitate va avea un complex sportiv complet. Un bărbat sau o femeie incapabili să meargă 10 mile (16,1 Km) dintr-o bucată va fi considerat slăbănog, nevolnic.”
O să omorâm toți caii.
“Nu vor mai exista țânțari sau muște. Plasele contra insectelor nu vor mai fi necesare. Țânțarii, muștele și gândacii domestici vor fi practic exterminate. Agențiile de sănătate vor distruge țânțarii și terenurile în care aceștia se înmulțesc, vor fi asanate apele stătătoare, vor fi umplute mlaștinile și vor fi tratate chimic cursurile de apă prea lente. Exterminarea cailor și dărâmarea grajdurilor vor reduce musculițele de casă.”
Elevii vor învăța cu ajutorul unor căști speciale.
Imaginează-ți cum cărțile vor fi introduse într-o mașină specială care va transmite cunoașterea direct în creierul elevilor.
Vom transmite imagini la mare distanță.
“Fotografiile vor fi telegrafiate de la orice distanță. Dacă peste un veac va fi o bătălie în China, imagini ale unui astfel de eveniment izbitor vor fi transmise în ziare (jurnale) o oră mai târziu. Chiar și astăzi fotografiile sunt telegrafiate la distanțe scurte. Fotografii vor reproduce natura în culori.”
Telefoanele vor fi capabile să apeleze în toată lumea.
“Telefonul fără fir și circuitele de telegraf se vor răspândi în toată lumea. Un soț aflat în mijlocul oceanului Atlantic va fi capabil să converseze cu soția aflată în dormitorul ei din Chicago. Vom putea să telefonăm în China la fel de ușor cum vorbim din New York în Brooklyn. Printr-un semnal automat, telefoanele se vor conecta cu orice circuit din localitate, fără intervenția telefonistei (poreclită ‘hello girl’).”
Oamenii vor folosi comunicații asemănătoare cu Skype.
“Cunoscut la acel timp ca ‘film de corespondență‘, era o versiune ”ultimul răcnet” a vremii pentru conferințe video. Fiecare participant la conversație își vedea partenerul pe un mare ecran de film în timp ce vorbea la un aparat de tip fonograf. Era necesară o a doua persoană care să opereze un echipament similar telegrafului.”
Vom crea hrană modificată genetic.
“Peste o sută de ani, nepoții noștri vor mânca la masa de Crăciun căpșuni mari cât merele. Zmeura și murele vor fi la fel de mari. Una va ajunge pentru masa unei persoane. Căpșunile și afinele vor crește în tufe înalte. Afinele și coacăzele vor fi mari ca portocalele. Un singur pepene galben va hrăni o întreagă familie. Pepenii, cireșele, grapefruit-ul, prunele, merele, perele și strugurii vor fi toate fără sâmburi. Curmalele și smochinele vor fi cultivate pe întreg teritoriul Statelor Unite.”
Toată lumea va avea avion personal.
Ți-ar place să ai propriul avion de o persoană cu care să ajungi oriunde în lume?
Cum să-i provoci pe elevi să discute:
Atunci când ne uităm la prezicerile din trecut, acestea ne pot spune multe despre contextul istoric al oamenilor care au trăit cu mult timp în urmă, dar ele ne pot da și indicii despre ce se va întâmpla în viitor.
Gândiți-vă că, în anul 1900 era fantastic să te gândești că ”Un soț aflat în mijlocul oceanului Atlantic va fi capabil să converseze cu soția aflată în dormitorul ei din Chicago.” Dar iată-ne astăzi, după abia 100 de ani de când a fost făcută această prezicere și acest tip de comunicații este de mult ceva banal.
Iată și predicții făcute în anii 1950 – https://gizmodo.com/robert-heinleins-predictions-for-the-year-2000-from-19-5871053
Opțiuni pentru întrebările care să provoace discuția elevilor:
- În 1900 oamenii abia ieșiseră din Revoluția Industrială, așa că nu este o surpriză faptul că au prezis că, în viitor vom prelua controlul naturii – de exemplu eliminând specii întregi de animale și insecte. Gândindu-ne la preocupările actuale pentru protecția speciilor amenințate (#1), este oare această prezicere pe cale să devină adevărată?
#1 https://defenders.org/publications
- Crezi că uciderea cailor este o metodă rezonabilă pentru a elimina muștele? Din 1900 până acum, ce progres s-a făcut pentru a controla populațiile de insecte dăunătoare? Ce preocupări legate de aceste metode avem astăzi? Crezi că în viitor vom continua să folosim pesticidele (#2) pentru a combate infestarea cu insecte?
#2 https://www.thepestinformer.com/safer-pest-control-project-acquisition/
- Pentru oamenii de acum 100 de ani, transportul a fost în mod clar o preocupare importantă. Noi deja am izbutit să călătorim pe calea aerului (deși încă nu am văzut prea multe avioane personale) Ce progrese crezi că se vor face în următorii 100 de ani în domeniul transportului?
- Poate că cele mai corecte preziceri despre anul 2000, făcute în prima partea a Secolului XX au fost cele din aria comunicațiilor. Acum putem de fapt să trimitem fotografii (și chiar filme) la mari distanțe, putem telefona la orice distanță și putem utiliza ”filmul pentru corespondență” (pe care îl numim acum video-conferință). Încotro crezi că se va îndrepta tehnologia comunicațiilor în viitor?
- În mod clar americanii din anii 1900 aveau o părere foarte bună despre Statele Unite și credeau că și oamenii din alte țări aveau o părere la fel de bună. Crezi că opiniile oamenilor despre SUA s-au schimbat între anii 1900 și 2000? Crezi că va veni o vreme când alte țări vor căuta să facă parte din Statele Unite? De ce, sau de ce nu?
- Ce crezi despre prezicerea legată de puterea fizică grozavă pe care urma să o aibă oamenii în anul 2000? Care sunt preocupările moderne legate de sănătate (#3) care sugerează că acea predicție nu a fost tocmai exactă? Crezi că, ca societate, ne vom îmbunătăți sănătatea fizică, sau vom continua să ne luptăm cu obezitatea?
#3 https://templatelab.com/task-force-on-childhood-obesity-report/
- Astăzi noi chiar utilizăm ingineria genetică pentru multe varietăți de alimente. Care sunt unele din preocupările pe care le avem acum legate de plantele, fructele modificate genetic (#4)? #4 https://www.globalissues.org/article/197/ge-food-links
- Deși prezicerea despre învățarea în clasă prin intermediul unor căști speciale nu a devenit adevărată, ce progrese crezi că se vor face în următorii 100 de ani în domeniul tehnologiei de învățare utilizate în clase? Gândește-te la unelte de acum, cum sunt whiteboard, e-books, iPads, platforme Web 2.0 și mediile de învățare virtuale – nici una dintre acestea nu a existat în primii ani ai Secolului XX. Cum se vor schimba acestea sau ce noi tehnologii le vor lua locul?
- Care este invenția care speri cel mai mult să apară în următorii 100 de ani? De ce? Crezi că este posibil să se întâmple?
Sursa: https://www.educationworld.com/a_curr/lesson-plan-booster/predicting-the-future.shtml
P.S. Puteți folosi aceste teme și întrebări la orele de istorie, la orele de limba română – ca provocări pentru eseuri individuale sau la orele de tehnologie digitală, ca provocări pentru viitoarele proiecte cu care să se prezinte elevii voștri la Concursul Digital Nerds 🙂